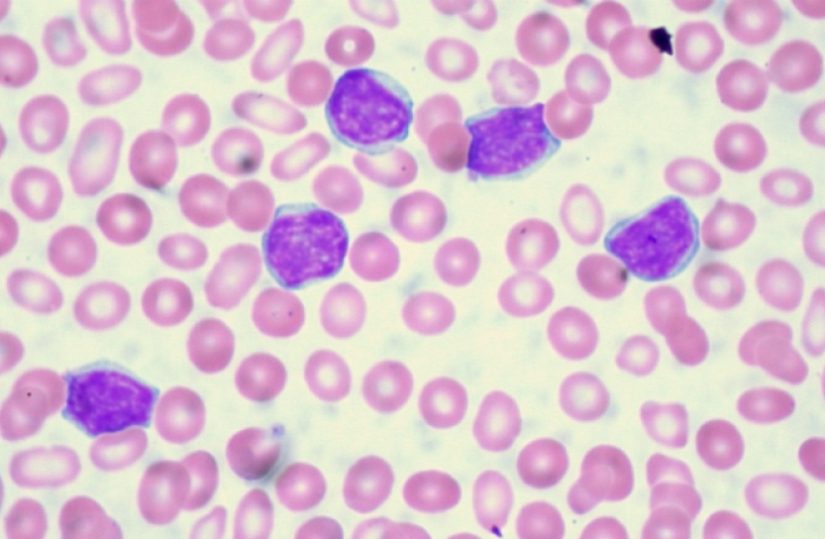

11 Jan 2019
Gripe: Portugal já entrou em fase epidémica
De acordo com o Instituto Nacional de Saúde Doutor Ricardo Jorge (INSA), a taxa de incidência de gripe foi de...11 Jan 2019
CHCB e centros de saúde intensificação cooperação devido à gripe
Em comunicado enviado às redações, a Administração Regional de Saúde do Centro (ARSC) especifica que a medida entra em vigor...10 Jan 2019
OM analisa queixa sobre médico afastado do INEM
De acordo com o bastonário da OM, Miguel Guimarães, o caso está agora nas mãos do conselho disciplinar do Sul...10 Jan 2019
Tutela estabelece “caráter prioritário” do novo Hospital Central do Alentejo
“O Conselho de Ministros aprovou hoje a resolução que estabelece o caráter prioritário da concretização do projeto de investimento no...10 Jan 2019
CHBM: Unidade de Senologia reconhecida pela Breast Centres Network
A Breast Centres Network é a primeira rede internacional de centros clínicos dedicados exclusivamente ao diagnóstico e tratamento do cancro...10 Jan 2019
SPGS organiza tertúlia sobre vantagens e desvantagens das PPP e EPE
Deste vez, o tema é sobre as “Vantagens e Desvantagens das PPP’s e EPE’s”, contando com a participação de vários...10 Jan 2019
CDS quer ouvir ministra sobre renúncia da administração do S. João
“Vemos com muito preocupação a notícia da demissão em bloco da administração do Hospital de São João, com uma explicação...10 Jan 2019
Ministra: SNS 24 é a melhor alternativa às urgências
Em declarações aos jornalistas, depois de ter visitado o Centro de Contacto do Serviço Nacional de Saúde (SNS 24), Marta...10 Jan 2019
Administração do São João pede renúncia de funções
“O Ministério da Saúde teve conhecimento do pedido de renúncia do Conselho de Administração do Centro Hospitalar Universitário de São...09 Jan 2019
Madeira reforça plano de contingência devido ao aumento das infeções respiratórias
“A partir de amanhã [quinta-feira] temos uma consulta aberta das 14:00 às 20:00, que vai funcionar de segunda a sexta-feira,...09 Jan 2019
ULS da Guarda anuncia contratação de novos profissionais de saúde
Em comunicado, a ULS refere que vai “iniciar de imediato procedimentos” para celebrar os contratos de modo a que “estes...09 Jan 2019
Algarve: Unidades de saúde preparadas para pico da gripe
“A situação é calma, estável e a afluência é inferior, em termos de números de casos de gripe, à do...09 Jan 2019
Fernando Falcão Reis é o novo presidente da SPO
“Os objetivos a curto prazo da nova direção passam por manter a SPO a funcionar com o mesmo dinamismo e...09 Jan 2019
AbbVie apresenta novos dados do estudo de fase III MURANO
Com uma mediana de seguimento de 36 meses, os resultados demonstraram que a maioria dos doentes com leucemia linfocítica crónica...09 Jan 2019
Nova Iorque: Autoridades anunciam plano de assistência médica universal
“A assistência médica é um direito, não um privilégio reservado àqueles que podem pagar”, assegurou o autarca de Nova Iorque,...09 Jan 2019